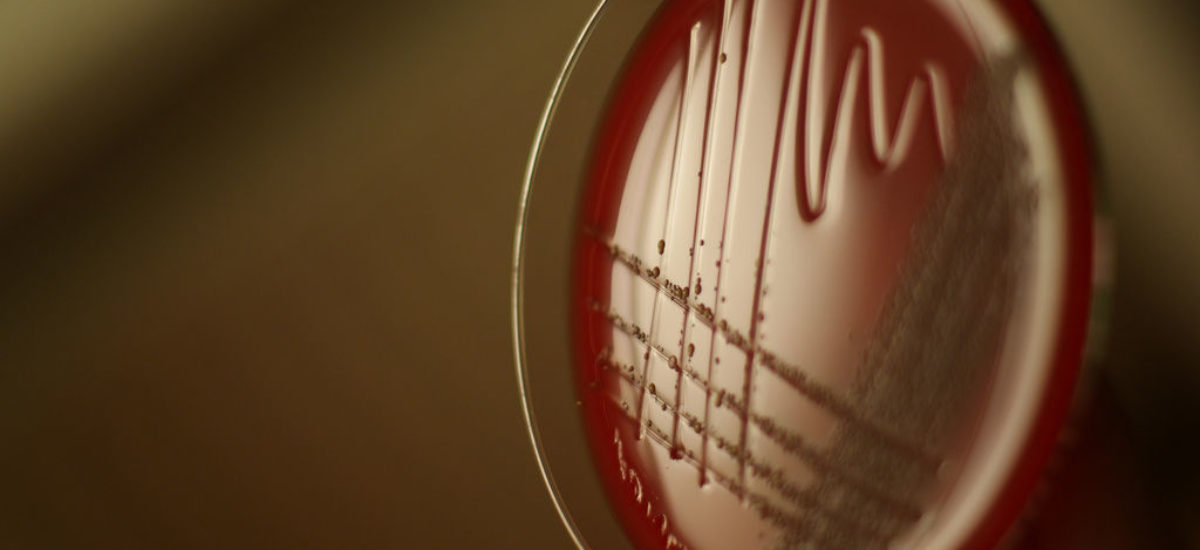
img_bacteria.adn_.hd_-3 Img bacteria adn hd

Las esporas toxigénicas de Clostridium difficile y las que causan intoxicación alimentaria de Clostridium perfringens muestran una prevalencia similar en alimentos como la carne. Ambas son resistentes a los procesos de calor y pueden sobrevivir, por tanto, a la cocción. Si bien ya se conoce que C. perfringens es una causa importante de enfermedades de transmisión alimentaria, un estudio realizado por expertos del Instituto de Investigación de Alimentos (Norwich, Reino Unido) apunta que son necesarias más investigaciones para determinar si C. difficile sigue una ruta similar. El artículo detalla cuáles son las particularidades de ambas bacterias y cuál es la relación entre clostridios y alimentos.
Uno de los clostridios más conocidos es Clostridium botulinum, responsable del botulismo. Pero dentro de este mismo género hay otros patógenos asociados a toxiinfecciones alimentarias: C. perfringens y C. difficile, dos productores de toxina que entran en el tracto digestivo, en la mayoría de los casos con consecuencias leves a moderadas sobre la salud.
Tanto C. difficile como C. perfringens pueden afectar a los alimentos, en particular carnes, pero también verduras y mariscos, y producen esporas resistentes al calor. Ambas pueden afectar a la carne y sobrevivir a temperaturas y tiempos recomendados de cocción, aunque el potencial de C. difficile de transmitirse a través de los alimentos se ha discutido en numerosas ocasiones.
Se necesitan, por tanto, más investigaciones para determinar cuáles serían las condiciones en las que las esporas de C. difficile pueden germinar y multiplicarse en platos de carne cocinada, si estas esporas persistirían y si darían lugar a una infección asintomática o sintomática después del consumo de la carne.
Particularidades de C. perfringens y C. difficile
C. perfringens se encuentra sobre todo en la superficie de las canales de algunos animales recién sacrificados, aunque también en aves de corral, pescado, hortalizas y productos lácteos. En la mayoría de los casos los brotes detectados se deben al consumo de comidas preparadas para gran número de personas, como es el caso de escuelas u hospitales. Una de las particularidades es que las esporas suelen sobrevivir en las grietas internas de los alimentos, quedando atrapadas en condiciones de anaerobiosis en el interior, donde germinan después de que el calor haya proporcionado el choque térmico necesario para que se activen.
Quedan por resolver dudas sobre cuáles son las condiciones necesarias para una mayor detección de C. difficile
La supervivencia de esporas no se produce solo por el tratamiento de cocción, sino también por una conservación a una temperatura que permite la multiplicación de este microorganismo (C. perfringens) a concentraciones elevadas. Esta bacteria se asocia a una deficiente conservación de los alimentos a temperaturas de refrigeración tras la cocción o a un recalentamiento deficiente.
C. difficile se ha detectado en el tracto intestinal de animales destinados al consumo, como vacas, cerdos, ovejas y aves de corral. Según el estudio británico, las esporas de esta bacteria pueden ser menos resistentes al calor que las de C. perfringens, aunque ambas pueden sobrevivir a procesos de cocción en los que se someten los alimentos a una temperatura interna de 70 ºC durante un máximo de dos minutos. La investigación determina que las esporas de ambas bacterias son susceptibles de sobrevivir a la cocción de la carne en las condiciones indicadas y, por tanto, pueden germinar y permitir el crecimiento de las bacterias, si el alimento se mantiene a temperaturas permisivas, que para C. difficile se sitúa entre los 30 ºC y los 37 ºC, ya que el organismo crece a 25 ºC-45 ºC.
No se conoce, sin embargo, la dosis infecciosa de esporas o bacterias vegetativas implicadas en la colonización que provoca enfermedad en personas vulnerables. Según la investigación británica, quedan por resolver dudas sobre cuáles son las condiciones anaeróbicas necesarias para una mayor detección de C. difficile, cuáles son las temperaturas que permiten el desarrollo, el efecto de la temperatura sobre la velocidad de crecimiento y la consecuencia de la combinación de factores, como el conservas caseras, y su existencia es fruto normalmente de una mala relación entre tiempo y temperatura. Para evitarla se necesitaría someter el producto a unos 90 ºC durante unos 50 minutos, proceso que podría reducir el riesgo de aparición de esporas.